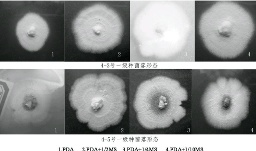
ZSYC2013030210001_s

【作者】 陈友; 胡佳娟; 陈勇敢;
【机构】 琼州学院; 三亚市第二中学;
【摘要】 以琼州学院灵芝栽培培养基配方为基础,对海南尖峰岭两种野生灵芝的一、二、三级菌种的培养基配方进行筛选试验结果,一级种较优培养基为PDA+1/4MS(马铃薯200g、葡萄糖20g、琼脂20g、1/4MS培养液、20mL的1/4MS培养基);二级种的较优培养基为Y1005(木屑78%、麦麸或米糠20%、蔗糖1%、石膏1%,含水量50%~60%),三级种的较优培养基为Y3102(木屑73%、黄豆粉5%、麦麸20%、蔗糖1%、石膏1%,含水量60%~65%)。
ManBetX体育 海南; 野生灵芝; 培养基; 配方; 筛选;
【文内图片】
不同培养基中灵芝一级种菌丝生长状况

不同培养基中灵芝二级种菌丝生长情况
【基金】 农业部热带种质资源保护项目《香蕉种质资源调查与收集》(12RZZY-47);琼州学院青年教师科研基金项目《海南野生香蕉驯化研究》(No.QY200917);三亚市院校专项资金项目《海南野生灵芝驯化研究》(No.YD09041)
【分类号】S567.31
